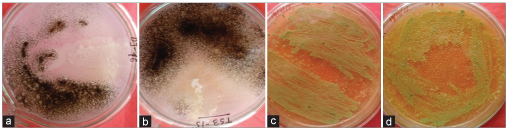

1. INTRODUCTION
In the present day, agricultural practices indiscriminate the use of fertilizers, particularly the nitrogen and phosphorus, has led to substantial pollution of soil, air, and water. Massive use of these chemical fertilizers showed detrimental effects on soil microorganism, affects the fertility status of soil and also pollutes environment [1]. The prolonged use of these often tends to a reduction in pH and exchangeable bases thus making them unavailable to crops and the production loss. During the past few years, the agricultural practices in India have undergone a major change through diversification and emphasis being given to sustainable production system. The rhizospheric microorganisms of plants become an important tool to protect the health of plants in an eco-friendly manner [2]. These microorganisms can affect plant growth often known as plant growth promoting rhizobacteria (PGPR) [3] and are involved in various biotic activities of the soil ecosystem to make it dynamic for nutrient turn over and sustainable for crop production [4].
In tea cultivation, the major nutrients are provided through chemical fertilizers; nitrogen as urea, sulfate of ammonia, and calcium ammonium nitrate, phosphorus as rock phosphate and potassium as muriate of potash. Researches on agronomics helped to increase tea production to a great extent. However, the repeated and continuous application of chemical fertilizers for decades changed the physicochemical properties of the soil. There was a reduction in organic matter content of the soil which leads to the reduction of beneficial soil microbes, which turn the soil infertile.
Nitrogen-fixing and phosphate-solubilizing bacteria are naturally present in almost all soils. However, their population level may not be sufficient to bring out these biological processes to a significant level. Application of efficient strains of these bacteria is successfully in practice in many crops. Preparations of such beneficial microorganisms, especially bacteria are commonly known as biofertilizers. In other words, “biofertilizers are carrier-based preparations containing beneficial microorganisms in a viable state.” They improve soil fertility and help in plant growth by improving nutrient availability.
A specific category of bacteria and fungi are treated with biofertilizers in tea and they are freely available in the surface soil and showed symbiotic relationship with plants. These organisms take nutrients from the plant tissue and instead of supply the required nitrogen and phosphorus to plants. The mycorrhiza, nitrogen-fixing bacteria, and phosphate-solubilizing bacteria are major biofertilizers available in tea soil.
Organic farming is mainly dependent on the naturally occurring microflora of the soil which constitutes all kinds of useful bacteria and fungi including the arbuscular mycorrhiza fungi called PGPR. Biofertilizers restore soil quality in respect of nutrients by nitrogen fixation, phosphate, and potassium solubilization or mineralization, production of plant growth regulating and antibiotic substances, and organic matter biodegradation in the soil [5,6] reported that when biofertilizers are applied as seed or soil inoculants, they multiply and plays a role in nutrient cycling and crop productivity. In general, 60–90% of the total applied fertilizer is lost and the remaining 10–40% is utilized by plants. In this aspect, microbial inoculants have paramount importance in integrated nutrient management systems to sustainable agricultural and healthy environment [7].
The rhizosphere is the narrow zone of soil surrounding plant roots and can comprise up to 1011 microbial cells per gram of root [8] and above 30,000 prokaryotic species that, in general, improve plant productivity [9]. Azotobacter plays a significant role in the nitrogen cycle in nature as it possesses a variety of metabolic functions [10].
Rhizosphere microflora is the unique identification of particular plant species. Hence, the rhizosphere microflora is credited with certain beneficial effects on crop nutrition and growth. Among the rhizosphere microflora, free-living diazotrophs have a unique position in nutrient mobilization as they can fix atmospheric N2 with the production of available N for the plants. In the recent years, both Azotobacter and Azospirillum received attention in crop production and soil health status. In most of the plantation crop such as rubber, tea, and coffee, application of Azotobacter and Azospirillum revolutionized the productivity of the crops investigated by several workers [11] reported the presence and distribution of some N2 fixing bacteria such as, Azotobacter, Azospirillum, Actinomycetes, rhizobium, and phosphate-solubilizing microorganism in the tea field [12]. Sood et al. (2007) have studied the importance of Bacillus and Pseudomonas in tea rhizosphere off for shaken tea bushes around some parts of Himalayan region in India. In general, the species Bacillus subtilis and Bacillus mycoides were known to be present in the roots of established tea plants and the abundance of Pseudomonas putida in the rhizosphere of abandoned tea bushes. They have shown that these bacteria were obvious for showing antagonistic pairs activities amongst themselves, which was probably due to the manufacture of bacteriocins by the isolates.
A diverse range of bacterial genera such as Arthrobacter, Azospirillum, Azotobacter, Bacillus, Pseudomonas, Klebsiella, Burkholderia, Erwinia, Flavobacterium, Micrococcus, Enterobacter, Xanthomonas, Chromobacterium, Serratia, and Caulobacter have been reported to promote plant growth [13,14]. The antagonistic effect of bacterium Citrobacter freundii ETR20 has been reported [15], and has potent effect on tea pathogenic (root rot) fungi Lasiodiplodia theobromae. From the perusal of literature, it has been revealed that there is very few or scanty reports on indigenous free-living soil bacteria to be as potent biofertilizer on tea crops and there antagonistic effect on tea pathogenic fungi. The object of this study is to evaluate the functional activity of some isolated and identified free-living bacteria as bioaccelerant or biofertilizer on tea field and their inhibitory activity of some tea pathogenic fungi which causes major crop loss.
2. MATERIALS AND METHODS
2.1. Materials
Six indigenous nonsymbiotic free-living soil bacteria isolated by same research group, namely, DS-1-20 (Stenotrophomonas sp. Accession No. KY636360
Terai: Latitude: 26.7271° N,
• Longitude: 88.3953° E
• Altitude: 329 ft.
• Temperature: 3°C minimum and 35°C maximum
Dooars: Latitude: 25° 58’ to 27° 45’ North
• Longitude: 89° 08’ to 89° 59’ East
• Altitude: 61m
Darjeeling: Latitude: 27° 2’ 9.6252’’ N
• Longitude: 88° 15’ 45.6192’’ E
• Altitude: 2,042 m
• Temperature 1.9°C minimum and 9.1°C maximum.
2.2. Preparation and Application of Biofertilizer
Six selected bacterial suspension culture (3-day-old, CFU-108/mL) has been mixed with sterilized charcoal powder at a ratio of 1:10 and applied in tea field @ 5 g/plant twice a year. The total experimental plot was divided into 24 random blocks. For each strain, four such block was allotted. Each block contains 120 plants. In pot plant single application of 10 g plant of biofertilizer has been made.
2.3. Field Trial
The field trial is conducted to evaluate the efficiency of overall performance of plant growth by some selected bacterial strain on the basis of total N content estimated by Kjeldahl Process. It is conducted for consecutive 2 years at Kamalpur Tea Estate, Terai to evaluate the efficiency of overall performance of plant growth (plucking point and green leaves yield) by six selected bacterial strain.
2.4. Pot Trial
Plant height, the girth of the plant, number laterals, and root length of six selected bacterial strain has also been conducted for 6 months at Rohini Tea Estate, Darjeeling low altitude. Following plant growth parameters has been considered in a pot plant.
2.4.1. Plant height (cm)
The height of the plant was measured from the base of the stem to fully opened top leaf and bud.
2.4.2. Root length (cm)
Plants were carefully uprooted and the root system was washed with water and root length was recorded by measuring the length from base of the stem to tip of the longest root.
2.4.3. Number of laterals
A total number of branches was recorded for each plant.
2.4.4. Stem girth (cm)
The diameter of stem at the three places was measured using vernier calipers, average diameter was taken and girth of the stem was calculated by using theformula 2πr.
One-way ANOVA of all the data has been performed using GraphPad Instat software.
2.5. Antagonistic Activity Assay
A study was performed to understand the antifungal activity of six selected bacterial strain against tea pathogenic fungi, namely, Alternaria alternata (MTCC No. 4123) and Phomopsis theicola (MTCC No. 373) obtained from IMTECH, Chandigarh by dual plate method [16]. The isolated bacterial strain was streaked in MA media (2 cm long lines) followed by incubation at 28 ± 2°C for 48 h. After appearance of normal growth of the bacteria, the culture plates were then overlaid with 10 mL of Potato Carrot Agar Media (potato 20 g, carrot 20 g, and agar 15 g for 1 L media) for A. alternata and oat meal agar (20 g oat infusion and 15 g agar for 1 L media) for P. theicola, respectively. The fungal spores (approximately 104 spore/ mL of media) of each strain were seeded separately on bacterial culture plate being covered with fungal media. The dual culture plate was incubated at 28 ± 2°C for 48 h and growth inhibition zone was observed.
3. RESULTS AND DISCUSSION
3.1. Field Trial Result
After application of selected screened bacterial strains such as, DS-1-20 (Stenotrophomonas sp), DS-2-10 (Herbaspirillum sp), DJ-1-22 (Burkholderia sp), DJ-1-3 (Burkholderia sp), TS-3-15 (Stenotrophomonas sp), and AS-1-4 (Stenotrophomonas sp) in tea fields for subsequent 2 years shows remarkable increase in yield (green leave production) and plucking point compare to the control. Among the six strains so far tested the DS-2-10, i.e.,, a bacterium of the genus Herbaspirillum sp. have showed a maximum response compare to the other five strains in the context of green leave production (145 kg in 1st year and 150.87 kg in 2nd year) [Table 1 and Figures 1 and 2] and plucking point (88.75 in 1st year and 91 in 2nd year) which are statistically significant (P < 0.001) [Table 2 and Figures 3 and 4]. It is evident from the result that the highest enhancement of green leaves production in 1st and 2nd year with the use of biofertilizer in compares to the control is 20.81%, and 25.40%, respectively. The production is also increases in the 2nd year (5% approx.) compare to that of 1st year. Influence of potassium solubilizing bacteria on the yield of tea plant has been investigated and showed 32% over production compare to that of control plant [17]. The increase in plucking point with the use of biofertilizer in compare to the control in the 1st year and the 2nd year is 8.89% and 11.65%, respectively. It has also been noted that the enhancement of plucking point of the 2nd year with that of 1st year is 2.76% [18]. Reported the free-living as well as the symbiotic association of Herbaspirillum sp. in tea root soil and both the properties of N2 fixing and PGPR activity. After DS-2-10, DS-1-20 a member of the genus Stenotrophomonas sp. shows the best response in the context of green leaves harvesting and plucking point. It is evident from the result that the production of green leaves and plucking point in the 1st year in all the six isolated bacterial strains is lower than that of 2nd year. It is presumably the somewhat additive function of biofertilizer in the 1st year and 2nd year.
 | Figure 1: Graphical presentation of green leaves harvested in first year. [Click here to view] |
 | Figure 2: Graphical presentation of green leaves harvested in the second year. [Click here to view] |
 | Figure 3: Graphical presentation of plucking point in first year. Significant at*** P<0.001, ** P<0.01, * P<0.05 level. [Click here to view] |
 | Figure 4: Graphical presentation of plucking point in second year. Significant at *** P<0.001, ** P<0.01 level. [Click here to view] |
 | Table 1: Green leaves of tea plant harvested (in 1st year) after treatment with selected biofertiliser. [Click here to view] |
 | Table 2: Effect of plucking point (1st and 2nd year) of tea plant treated with six bacterial strains [Click here to view] |
The effect of six selected bacterial strain in 1-year-old tea plant in pot condition showed a significant response. Among the four parameters so far studied (plant height, the girth of the plant, number of laterals, and root length) the number of laterals showed the most significant response in biofertilizer treated plant compare to that of control one. The maximum increase is observed in number of laterals (76.9% treated with DS-2-10, i.e., Herbaspirillum sp.) followed by root length (52% treated with both of DS-2-10, i.e., Herbaspirillum sp. and DJ-1-22, i.e., Burkholderia sp.), height of plant (50.86% treated with DS-2-10, i.e., Herbaspirillum sp.), and girth of the plant (40.62% treated with DS-1-20 i.e., Stenotrophomonas sp.) [Table 3 and Figures 5-8].
 | Table 3: Effect of selected bacterial strain on plant height, girth of the plant, number of laterals and root length of potted tea plant [Click here to view] |
 | Figure 5: Graphical presentation of effect of bacterial strain on the growth of plant girth. Significant at *** P<0.001, ** P<0.01 level. [Click here to view] |
 | Figure 6: Graphical presentation of effect of the bacterial strain on the plant height. Significant at *** P<0.001. [Click here to view] |
 | Figure 7: Graphical presentation of the effect of bacterial strain on the growth of root length. Significant at *** P<0.001. [Click here to view] |
 | Figure 8: Graphical presentation of the effect of bacterial strain on the growth of a number of laterals.Significant at*** P<0.001, * P<0.05 level. [Click here to view] |
The antagonistic activity among of all the isolated bacterial strain, DS-1-20 exhibit highest (24.6 mm diameter inhibition zone) positive response against A. alternata a plant pathogenic bacteria causes leaf blight of tea plant. TS-3-15 and DS-1-20 showed the highest (15.4 mm diameter inhibition zone) positive response against Fomes lamaensis tea pathogenic (causing brown root rot) fungi. DS-1-20 showed a positive response (15.5 mm diameter inhibition zone) against P. theicola, a tea pathogenic fungi (branch canker) [Figures 9 and 10, Table 4].
| Figure 9: Antagonistic effect of the representative isolated bacterial strain against (a) Alternaria alternata, (b) Fomes lamaensis, (c-d) Phomopsis theicola. [Click here to view] |
 | Figure 10: Graphical presentation of inhibiton the effect of bacterial strain on the growth pathogenic fungi. [Click here to view] |
 | Table 4: Antifungal activity (inhibition zone) of some selected bacterial strain. [Click here to view] |
4. CONCLUSION
Field and pot trial of selected DS-1-20, DS-2-10, and DJ-1-22, DJ-1-24, TS-3-15, and AS-1-4 bacterial strains performed satisfactory result in respect of yield, plucking point, plant height, root length, girth, and a number of laterals. Among isolated strain so far tested, Herbaspirillum showed good response both in field and pot application. These bacterial strains can be considered as potent biofertilizer in highly valued cash crop like tea plant toward the production of “Organic Tea.” Since the biofertilizer from foreign origin did not work well due to antimicrobial exudates produced by PGPR indigenous or garden specific bioacclerant would gave a better response.
5. ACKNOWLEDGMENT
The authors are thankful to the Secretary Oriental Institute of Science and Technology for providing the facilities to perform this work.
6. REFERENCES
1. Youssef MM, Eissa MF. Biofertilizers and their role in management of plant parasitic nematodes. E J Biotechnol Pharm Res 2014;5:1-6.
2. Akhter SM, Hossain SJ, Hossain SA, Datta RK. Isolation and characterization of salinity tolerant Azotobacter sp. Greener J Biol Sci 2012;2:43-51.
3. Kloepper JW, Leong J, Teintze M Schroth MN. Enhanced plant growth by siderophores produced by plant growth-promoting rhizobacteria. Nature 1980;286:885-6.
4. Ahemad M, Khan MS, Zaidi A, Wani PA. Remediation of herbicides contaminated soil using microbes. In: Khan MS, Zaidi A, Musarrat J, editors. Microbes in Sustainable Agriculture. New York, USA: Nova Science Publishers; 2009.
5. Sinha RK, Valani D, Chauhan K, Agarwal S. Embarking on a second green revolution for sustainable agriculture by vermiculture biotechnology using earthworms: Reviving the dreams of sir charles Darwin. Int J Agric Health Saf 2014;1:50-64.
6. Singh JS, Pandey VC, Singh DP. Efficient soil microorganisms: A new dimension for sustainable agriculture andenvironmental development. Agric Ecosyst Environ 2011;140:339-53.
7. Adesemoye AO, Kloepper JW. Plant-microbes interactions in enhanced fertilizer-use efficiency. Appl Microbiol Biotechnol 2009;85:1-12.
8. Egamberdieva D, Kamilova F, Validov S, Gafurova L, Kucharova Z, Lugtenberg B. High incidence of plant growth stimulating bacteria associated with the rhizosphere of wheat grown on salinated soil in Uzbekistan. Environ Microbiol 2008;10:1-9.
9. Mendes R, Garbeva P, Raaijmakers JM. The rhizosphere microbiome: Significance of plant beneficial plant pathogenic and human pathogenic microorganisms. FEMS Microbiol Rev 2013;37:634-63.
10. Sahoo RK, Ansari MW, Dangar TK, Mohanty S, Tuteja N. Phenotypic and molecular characterisation of efficient nitrogen-fixing azotobacter strains from rice fields for crop improvement. Protoplasma 2014;251:511-23.
11. Baby UI, Tensingh B, Ponmurugan P, Premkumar R. Effect of Azospirillum on nursery grown tea plants. In: Proceedings of the 15th Plantation Crops Symposium. (Sreedharan K, Vinodkumar PK, Jayarama, Chulaki BM, editors); 2002. p. 369-74.
12. Sood A, Sharma S Kumar V (2007) Comparative efficacy of diffusible and volatile compounds of tea rhizospheric isolates and their use in biocontrol. Int. J. Biol. Chem. Sci. 2007; 1: 28- 34.
13. Bhattacharyya PN, Jha DK. Plant growth-promoting rhizobacteria (PGPR): Emergence in agriculture. World J Microbiol Biotechnol 2012;28:1327-50.
14. Bal H, Das S, Dangar TK, Adhya TK. ACC deaminase and IAA producing growth promoting bacteria from the rhizosphere soil of tropical rice plants. J Basic Microbiol 2013;53:972-84.
15. Purkayastha GD, Saha A, Saha D. Characterization of antagonistic bacteria isolated from tea rhizosphere in sub-Himalayan West Bengal as potential biocontrol agents in tea. J Mycl Plant Pathol 2010;40:27-37.
16. Mandal V, Sen SK, Mandal NC. Detection, Isolation and partial characterization of antigungal compound(s) produced by Pediococcus acidilactici LAB 5. Nat Prod Comm NC 2007;2:671-4.
17. Bagyalakshmi B, Ponmurugan P, Marimurhu S. Influence of potassium solubilising bacteria on crop productivity and quality of Tea (Camellia sinensis). Afr J Agric Res 2012;7:4250-9.
18. Zhan G, Cheng W, Liu W, Li Y, Ding K, Rao H, et al. Infection, colonisation and growth promoting effects of tea (Camellia sinensis L.) by the endophytic bacterium Herbaspirillum sp. WT00C. Afr J Agric Res 2016;11:130-8.